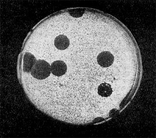

10399 (646494), страница 4
Текст из файла (страница 4)
Иллюстрация 14: Негативные колонии бактериофага средней величины. Увел. 1:1
Является ли процесс размножения фага всегда смертельным для инфицированной им клетки? Несомненно, абсолютное большинство фагов вызывают при размножении лизис клетки и ее гибель. Лишь в последнее время было установлено, что при инфицировании клетки нитевидными фагами возможно размножение их без гибели клетки.
Если произвести рассев по поверхности агаризованной питательной среды в чашках Петри смеси фага и чувствительных к нему микробов и чашки выдержать в термостате, то происходит лизис клеток в результате размножения фага. Если взять большое количество частиц фага, то лизируется большая часть или весь выросший газон культуры. Если количество фаговых частиц таково, что они распределяются только на отдельных участках газона, лизируя в этих местах культуру, то возникает колония фага.
Эти колонии фага получили название бляшек, стерильных пятен. Правильнее их называть негативными колониями. Каждая негативная колония состоит из десятков и сотен миллионов фаговых частиц. Размер негативных колоний и их форма зависят в первую очередь от свойств фага, а также от состава среды и культуры микробов. У одних фагов негативные колонии очень мелкие и еле видимы невооруженным глазом, другие достигают 10 мм в диаметре и более. Колонии бывают светлые и четкие, когда лизировалась вся культура, или мутноватые, когда лизировались не все клетки. Вокруг негативных колоний некоторых фагов могут возникнуть различной формы и величины ореолы. На рисунках 12— 16 показаны негативные колонии разных фагов.
Морфология негативных колоний служит одним из признаков, которым пользуются при дифференциации фагов.
Иллюстрация 15: Крупные негативные колонии актинофага. Увел. 1:1.
Иллюстрация 16: Негативные колонии актинофага, окруженные ореолом угнетенного роста тест-культуры. Увел. 10:8.
Лизогения и её биологическое значение
При изучении явления бактериофагии исследователи обратили внимание на то, что иногда встречаются культуры микроорганизмов, которые содержат фаги, хотя на эти культуры фагами и не воздействовали. Явление фагоносительства получило название лизогении.
Оно было описано одним из основоположников учения о бактериофагах — Д'Эреллем, который считал, что такие культуры загрязняются фагом извне. Подобные культуры были названы ложнолизогенными.
Ложнолизогенные культуры состоят из смеси устойчивых и чувствительных к определенному фагу клеток.
Такие культуры могут быть легко освобождены от содержащихся в них фагов или путем нескольких рассевов, или с помощью специфической антифаговой сыворотки, или воздействием антифаговыми веществами.
Кроме ложнолизогенных, встречаются такие содержащие фаги культуры, у которых лизо-генное состояние, т. е. способность выделять фаги, стойко сохраняется даже после многочисленных пересевов в среде с антифаговой сывороткой и многократных воздействий антифаговыми веществами. Такие культуры названы истиннолизогенными. Мы расскажем только об этих культурах, которые будем называть лизогенными.
Лизогенными культурами являются такие культуры, которые обладают способностью продуцировать зрелые частицы фага без воздействия на них фагом извне. Это свойство стойко передается по наследству. В лизогенной культуре фаг находится внутри клетки. Для понимания сущности лизогении особо важное значение имел вопрос: в каком состоянии фаг находится внутри лизогенной клетки?
Опыты с искусственным разрывом клеток лизогенных культур под влиянием разнообразных физических и химических факторов (ультразвука, антибиотиков, литических ферментов и т. д.) не выявили наличия в клетках зрелых частиц фага.
Важное значение для понимания истинной природы лизогении имели работы А. Львова и А. Гутмана (1950). Оригинальные опыты этих исследователей убедительно показали, что в лизогенной клетке фаг находится не в виде зрелых частиц, а в какой-то другой, неинфекционной для клетки форме. Такую форму назвали профагом. Именно умеренные фаги могут находиться в лизогенных клетках в виде профага.
Клетку можно экспериментально сделать лизогенной. Такой эксперимент помог выяснить механизмы процесса, благодаря которому клетка становится лизогенной. Оказалось, что при воздействии на клетку умеренным фагом часть популяции клеток лизируется, а другая часть становится лизогенной. При этом фаг адсорбируется клеткой и его нуклеиновая кислота проникает внутрь клетки. Однако, в отличие от продуктивной инфекции, вызываемой вирулентным фагом, при лизогенизадии нуклеиновая кислота фага связывается с ядерным аппаратом клетки (хромосомой) и остается в ней в виде профага.
Вопросы локализации профага в клетке и формы его связи с клеткой являются важнейшими проблемами лизогении. По данным ряда исследователей, каждый профаг занимает определенное место на хромосоме лизогенной клетки. При делении клетки профаг воспроизводится со скоростью, равной скорости воспроизводства генетического материала клетки, что способствует передаче лизогенного состояния потомству.
Следовательно, в лизогенной клетке профаг ведет себя как ее нормальный компонент. При лизогенизации происходит объединение генетического материала клетки с генетическим материалом фага на молекулярном уровне. Известны пока единичные случаи, когда профаг не связан с хромосомой, а расположен на мембранах клеточной цитоплазмы.
Итак, в лизогенной клетке фаг является дополнительным генетическим фактором, который может неопределенно длительное время находиться внутри клетки и, как всякий генетический фактор, определять свойственные ему признаки.
Лизогенные культуры устойчивы (или иммунны) к тому фагу, который они содержат, а также к близкородственным ему фагам. При размножении лизогенной культуры какая-то часть клеток популяции лизируется и освобождает зрелые частицы специфичного для этой популяции умеренного фага.
Образование лизогенными культурами зрелых частиц фага получило название спонтанной индукции. Количество лизируемых клеток и количество образовавшихся зрелых частиц фага зависят от особенностей данной культуры и условий выращивания. В то же время количество клеток, освобождающих фаги, может быть резко увеличено при воздействии на лизогенную культуру некоторыми физическими и химическими факторами, получившими название индуцирующих. При индукции некоторых лизогенных культур удавалось вызывать образование зрелых частиц фага почти у всех клеток. К индуцирующим агентам относятся ультрафиолетовые (УФ), рентгеновские и гамма-излучения, перекиси, азотистый иприт и его гомологи, этиленимин, урацил, многие антибиотики. Наиболее эффективные и широко применяемые индуцирующие факторы — УФ-лучи и антибиотик митомицин С.
Как отмечалось, важным свойством лизогенной культуры является ее устойчивость к содержащемуся в ней фагу. В связи с этим выделение и изучение умеренных фагов лизогенной культуры возможно лишь в том случае, когда имеется другая культура того же вида, которая чувствительна к умеренному фагу данной лизогенной культуры. Такие культуры получили название индикаторных. К лизогенным культурам, особенно широко распространенным в природе, сравнительно легко можно подобрать индикаторные культуры среди других разновидностей этого же вида.
В отдельных случаях умеренный фаг лизогенной культуры может спонтанно (без внешних воздействий) или под влиянием различных факторов измениться и стать вирулентным. Тогда фаг приобретает способность лизировать все клетки данной культуры. У некоторых лизогенных культур превращение умеренного фага в вирулентный происходит сравнительно легко. Имеется ряд культур, у которых экспериментально не удавалось превратить умеренный фаг в вирулентный.
Возможность возникновения вирулентных мутантов умеренных фагов имеет большое теоретическое и практическое значение. Не редки случаи, когда единственным доказательством лизогенности культуры является возникновение вирулентных мутантов ее умеренного фага.
Лизогения широко распространена среди всех систематических групп микроорганизмов. Это явление детально изучено у сальмонелл — возбудителей брюшного тифа и паратифа, у дифтерийной палочки; все культуры этих видов патогенных бактерий оказались лизогенными. Лизогения широко распространена среди стрептококков, споровых форм бактерий, клубеньковых бактерий, актиномицетов, микобактерий и др.; она выявлена и у некоторых мицелиальных грибов (пенициллов) и дрожжей. Есть все основания утверждать, что абсолютное большинство микроорганизмов являются лизогенными. Ни про одну культуру нельзя с уверенностью сказать, что она не лизогенная.
За последнее время накапливается все больше данных о том, что многие лизогенные культуры содержат 2, 3, 4 и более умеренных фагов, т. е. являются полилизогенными. Например, многие актиномицеты, проактиномицеты, клубеньковые бактерии и некоторые спороносные бактерии содержат 4 и более фагов. Содержащиеся в полилизогенных культурах фаги часто резко различаются между собой по форме частиц, антигенным свойствам и спектру литического действия. Полилизогенные культуры можно экспериментально получить с помощью воздействия на них одновременно или последовательно различными умеренными фагами. Полученные таким способом культуры не отличаются от выделенных из природных источников.
Как уже отмечалось, профаг лизогенной культуры способен превратиться спонтанно или при индукции в зрелую полноценную фаговую частицу. Однако в ряде случаев под влиянием различных факторов у профага возникают стойкие наследуемые изменения (мутации), в результате которых он при индукции не способен превращаться в полноценную частицу. Поэтому у таких культур возникают частицы, состоящие только из головки или только из одного отростка. Возможны и другие нарушения в структуре фаговой частицы. При индукции таких культур лизогенная клетка лизируется, но образовавшиеся частицы как неполноценные не способны к размножению на индикаторной культуре.
Наиболее детально изучены дефектные фаги, у которых образуются одни лишь отростки. Такие фаги способны адсорбироваться на клетке, убить ее, но не могут размножаться. В последнее время такие дефектные фаги привлекли к себе внимание исследователей, так как было установлено, что многие описанные в литературе бактериоцины (вещества, убивающие бактерии) представляют собой дефектные фаговые частицы.
Существуют два принципиально различных типа бактериоцинов. Одни из них отличаются низким молекулярным весом, не осаждаются при центрифугировании, чувствительны к ферменту трипсину, термолабильны и в электронном микроскопе не видны. Бактериоцины другого типа обладают высоким молекулярным весом, осаждаются при центрифугировании, термостабильны и в электронном микроскопе видны в виде фагоподобных частиц или отдельных компонентов фаговой частицы (преимущественно в виде отростков).
О происхождении бактериоцинов первого типа и о возможной связи их с лизогенным состоянием культуры-продуцента никаких данных нет. В то же время многими исследователями показано, что образование бактериоцинов второго типа тесно связано с дефектной лизогенией продуцента.
Наиболее убедительное доказательство дефектной лизогении — выявление дефектных фаговых частиц, количество которых значительно увеличивается при индукции.
Имеются все основания утверждать, что дефектная лизогения довольно широко распространена. Она выявлена у очень многих культур, например у актиномицета, продуцирующего антибиотик стрептомицин, клубеньковых бактерий, спороносных бактерий, применяемых для борьбы с вредными насекомыми. Выявлены дефектные фаговые частицы, обнаруженные у кишечной палочки и названные колицином. Кроме того, были выявлены и описаны полилизогенные культуры актиномицетов, которые одновременно содержали нормальные и дефектные фаговые частицы.
Как уже отмечалось, профаг в лизогенной культуре связан с ядерным аппаратом клетки и является дополнительным генетическим фактором. Профаг в лизогенной клетке ведет себя как ген, хотя между ними имеются принципиальные различия. За последние годы достигнуты большие успехи не только в изучении сущности лизогении, но и в выяснении роли профагов как дополнительных генетических факторов. Изменения, вызываемые профагом в лизогенной клетке, получили название лизогенных конверсии.
Лизогения, несомненно, одно из самых интересных явлений в биологии микроорганизмов, теоретическое и практическое значение которого далеко выходит за пределы микробиологии. Изучение этого явления сыграло большую роль в формировании представлений о фагах, их происхождении, о взаимоотношениях фагов с клеткой-хозяином.
Не исключено, что лизогенизация является одним из механизмов защиты микробной клетки от фаговой инфекции, выработанным клеткой в процессе длительной эволюции. Лизогенизация в известной степени биологически выгодна и клетке, и фагу. Клетка при лизогенизации становится устойчивой не только к данному фагу, но и к родственным ему фагам и, кроме того, приобретает дополнительные свойства.
Фаг же приобретает устойчивость к разнообразным внешним воздействиям и в то же время сохраняет потенциальную возможность перейти в вегетативное состояние и в состояние зрелой инфекционной частицы. Широкое распространение лизогении дает основание рассматривать это явление не как исключительное, а как нормальное на данном этапе эволюции микробов.